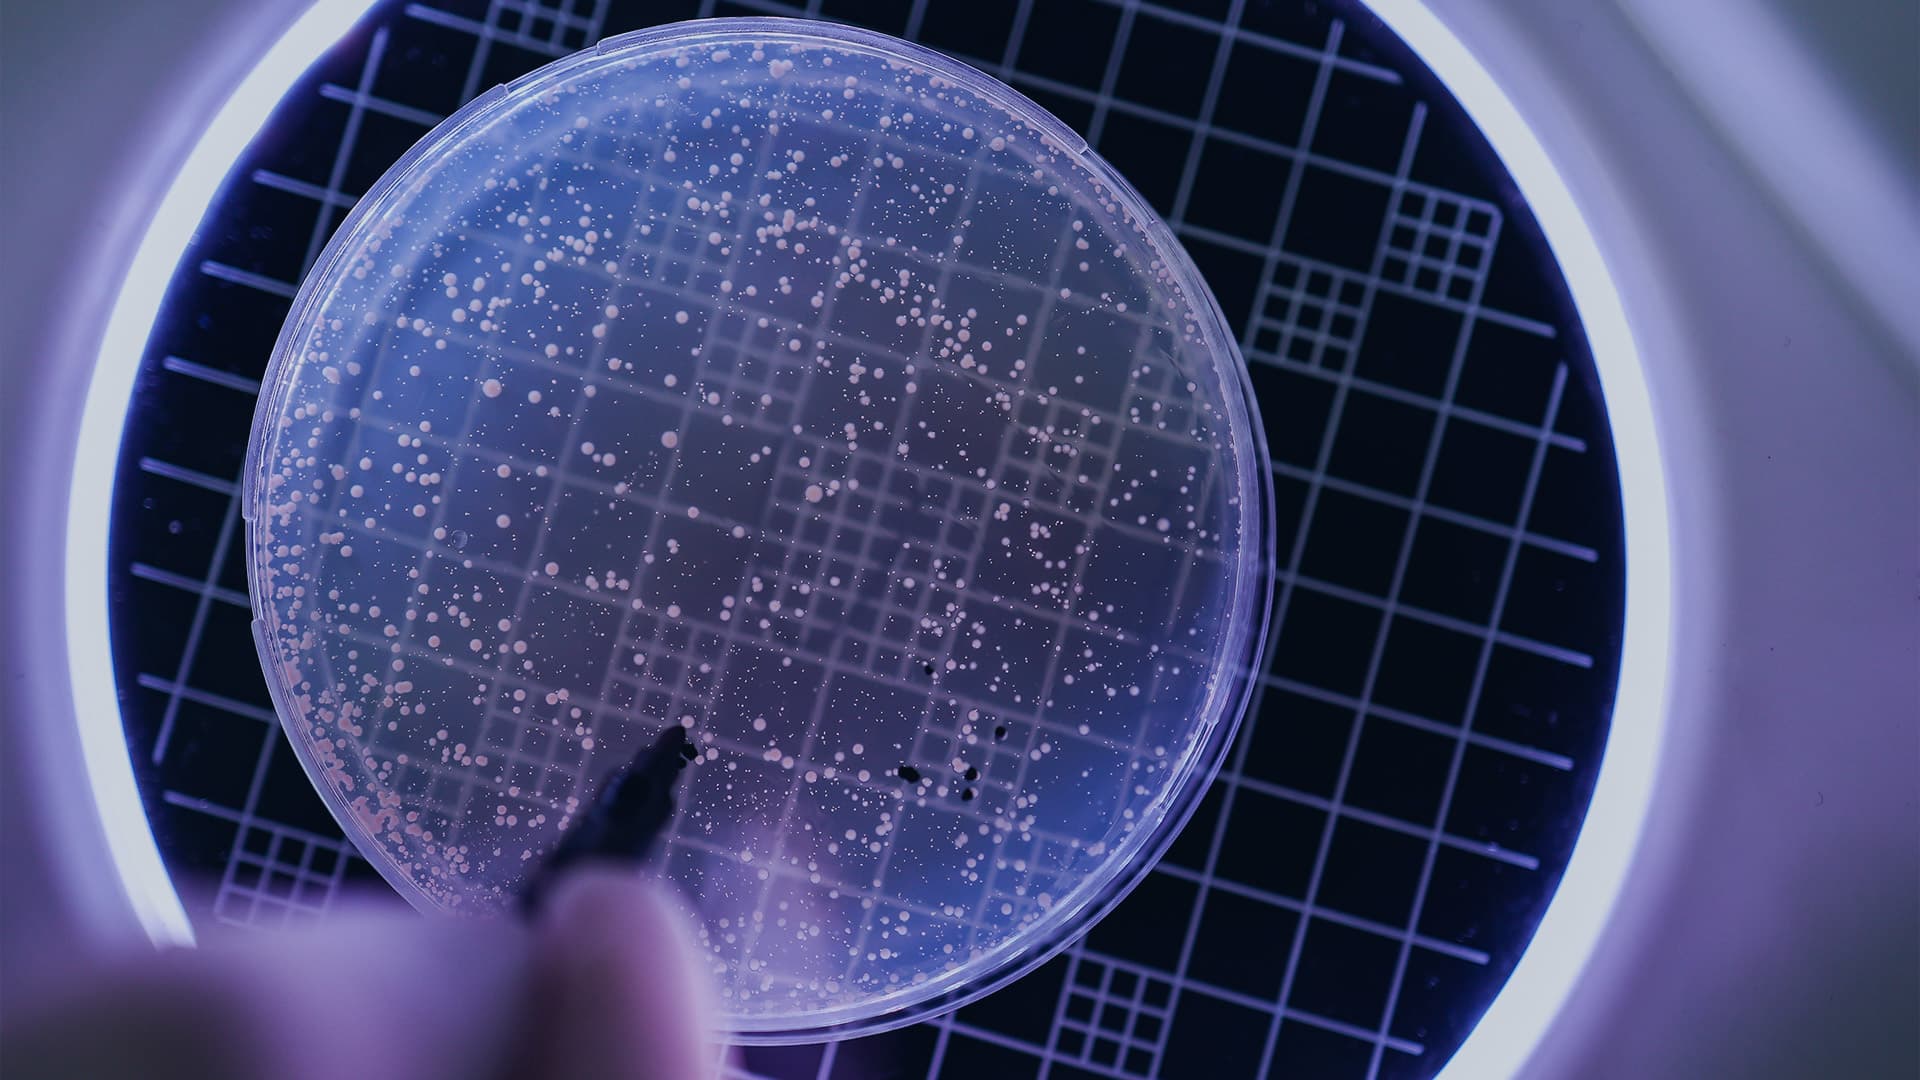

CMC / R&D Recruitment
Entrust your company’s CMC / R&D recruitment needs to EPM Scientific. The preferred talent partner of leading life sciences companies, we understand the importance of chemistry, manufacturing, and controls (CMC) in ensuring consistency and quality throughout the drug development and manufacturing process.
Don’t leave your company’s CMC recruitment to chance. Our talent experts will find and place the best people for your open roles, forging a relationship that will support your company’s ongoing evolution as it moves towards actualising its objectives and fulfilling its mission statement. Benefit from more than 10 years of industry experience by making EPM Scientific your company’s first choice for CMC and R&D recruitment.
Find the best CMC / R&D talent for your company.
Why choose EPM Scientific for CMC / R&D recruitment?
EPM Scientific’s mission goes beyond premium CMC / R&D recruitment services to include ongoing assistance and support. When you choose us for R&D and CMC staffing services, your organisation can benefit from:
Considerable industry experience
EPM Scientific has collaborated with life sciences companies for over a decade, providing them with premium R&D and CMC recruitment services and additional offerings. Thanks to our recruiters’ considerable experience and understanding of the industry’s challenges and the opportunities it offers, we can deliver the talent that your company needs, when it needs it.
Customised recruitment services
Our talent experts will begin the process of sourcing talent for your life sciences organisation by working with you to ensure that we understand your company's hiring needs, vision, and values. When we know exactly what we’re looking for, we will adapt our R&D and CMC recruitment processes, strategies, and services to ensure that we find highly sought-after individuals who will be assets to your organisation.
Innovative vision
Innovation and the development of new drugs and medical devices go hand-in-hand. Without vision, life sciences organisations cannot adapt, evolve, or survive. Choose EPM Scientific as your preferred R&D recruitment agency and ensure that your company benefits from talent that makes it possible to innovate continually and stay ahead of trends.
A supportive partnership
While your organisation’s relationship with EPM Scientific may begin with CMC and R&D recruitment, it can continue through additional recruitment when needed and through further bespoke services such as talent analysis and employer value propositions, supporting your organisation as it grows and evolves to achieve its goals.
With our extensive network and strong partnerships, we place top talent quickly, simplifying your hiring process.
With all this and more to offer, it’s not surprising that leading life sciences organisations and innovative startups around the world choose EPM Scientific for R&D and CMC staffing services. Let us revolutionise your company’s approach to R&D recruiting.
EPM Scientific’s expertise covers the full life cycle of product development within life sciences including:
- Associate Director Regulatory CMC
- Senior Manager Regulatory CMC
- Director Regulatory CMC
- CMC Consultant
- Head of CMC
- R&D Manager
- Associate Director Manufacturing
- Mechanical Engineer
- Director of Product Development
- Director of Analytical R&D
Work with a trusted CMC / R&D recruitment agency.

Looking to secure the best CMC / R&D talent?
Whether your life sciences company is established or a startup, there is no need to limit CMC / R&D recruiting to a potentially small pool of local candidates. Choose EPM Scientific as your organization’s R&D and CMC recruitment agency and gain the competitive advantage that comes with exceptional talent and superb value-added services such as salary benchmarking and a variety of resources tailored to your company’s needs.
CMC / R&D Recruitment
EPM Scientific offers various workforce solutions tailored to your specific objectives.
Permanent hires
Our permanent search service, whether through contingent or retained medical affairs recruitment, helps you secure the professionals who can truly make an impact.
Contract hires
Our extensive network of contractors and interim managers integrate seamlessly into companies to drive short term goals.
Multi-hire projects
We take a consultative approach with our clients, managing the entire recruitment process from sourcing to hiring.